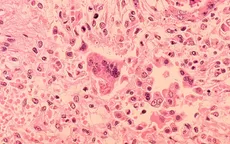

tử vong do biến chứng sởi
Trẻ tử vong do biến chứng sởi hiếm gặp tại Los Angeles (Mỹ)
VTV.vn - Một trẻ trong độ tuổi đi học tại Quận Los Angeles (Mỹ) đã tử vong do biến chứng hiếm gặp của bệnh sởi sau khi mắc bệnh từ khi còn nhỏ.
